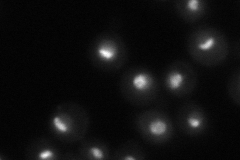
YJL033W

View description
Putative nucleolar DEAD box RNA helicase; high-copy number suppression of a U14 snoRNA processing mutant suggests an involvement in 18S rRNA synthesis
Localization:
Intensity:
Fold change:
Significance:
-
C’ GFP library in SD

nucleolus65.6 -
N' NOP1pr-GFP in SD

nucleolus85.3878 -
N' TEF2pr-mCherry in SD

nucleus,nucleolus77.2007 -
N' NATIVEpr-GFP in SD
nucleus,nucleolus65.5696 -
N' TEF2pr-VC and Cyto-VN in SD

nucleus,nucleolus40.7584 -
C’ GFP library in SD+DTT

nucleolus45.230.68No -
C’ GFP library in SD+H2O2

nucleolus68.961.05No -
C’ GFP library in Starvation Media

nucleolus29.740.45Yes -
C’ GFP library on the background of Pup2-DaMP

nucleolus -
C’ GFP library on the background of CCT mutant

nucleolus77.35861.17911No
